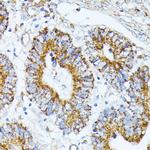
TRAP1 Antibody in Immunohistochemistry (Paraffin) (IHC (P))

Search
Invitrogen
TRAP1 Polyclonal Antibody
{{$productOrderCtrl.translations['antibody.pdp.commerceCard.promotion.promotions']}}
{{$productOrderCtrl.translations['antibody.pdp.commerceCard.promotion.viewpromo']}}
{{$productOrderCtrl.translations['antibody.pdp.commerceCard.promotion.promocode']}}: {{promo.promoCode}} {{promo.promoTitle}} {{promo.promoDescription}}. {{$productOrderCtrl.translations['antibody.pdp.commerceCard.promotion.learnmore']}}

Please note: We are reviewing Western blot images included in the antibody testing data in our catalog, including those provided by third parties. Unless expressly labeled or annotated as “raw-unedited”, Western blot images included in the antibody testing data in our catalog may have been edited, optimized or otherwise adjusted for presentation.
产品信息
PA5-96201
种属反应
宿主/亚型
分类
类型
抗原
偶联物
形式
浓度
规格
纯化类型
保存液
内含物
保存条件
运输条件
RRID
产品详细信息
Positive Samples: SW620, MCF7, Jurkat, BxPC-3, Mouse kidney, Mouse skeletal muscle, Mouse heart, Mouse brain; Cellular Location: Mitochondrion, Mitochondrion inner membrane, Mitochondrion matrix
Immunogen sequence: GLFMREGIVT ATEQEVKEDI AKLLRYESSA LPSGQLTSLS EYASRMRAGT RNIYYLCAPN RHLAEHSPYY EAMKKKDTEV LFCFEQFDEL TLLHLREFDK KKLISVETDI VVDHYKEEKF EDRSPAAECL SEKETEELMA WMRNVLGSRV TNVKVTLRLD THPAMVTVLE MGAARHFLRM QQLAKTQEER AQLLQPTLEI NPRHALIKKL NQLRASEPGL AQLLVDQIYE NAMIAAGLVD DPRAMVGRLN ELLVKALERH
靶标信息
The 90 kDa heat shock protein (hsp90) family of molecular chaperones is a highly conserved family of proteins that play an important physiological role. Hsp90 is involved in numerous cellular processes but is best known for its association with signal transduction machinery. A recently cloned homolog of hsp90 is the tumor necrosis factor receptor-associated protein (TRAP1). Like hsp90, TRAP1 is found to be associated with numerous proteins involved in diverse actions. Immunofluorescence data has shown TRAP1 to be localized in the mitochondria of mammalian cells. This observation and the fact that TRAP1 is shown to have a mitochondrial targeting presequence strongly implicates TRAP1 as a mitochondrial matrix protein.
仅用于科研。不用于诊断过程。未经明确授权不得转售。
篇参考文献 (0)
生物信息学
蛋白别名: Heat shock protein 75 kDa, mitochondrial; HSP 75; TNFR-associated protein 1; TRAP-1; tumor necrosis factor type 1 receptor associated protein; Tumor necrosis factor type 1 receptor-associated protein
基因别名: 2410002K23Rik; HSP75; Hspc5; Trap1
UniProt ID: (Rat) Q5XHZ0, (Mouse) Q9CQN1
Entrez Gene ID: (Rat) 287069, (Mouse) 68015




